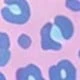
Purple

SHEIN Baby Girls Casual Striped Ruffle One-Piece Swimsuit, Bathing Suits For Toddlers
SKU: sa25031299787796221
Price and availability
69kr
Color:Multicolor
Large Image

Size
6-9M (68-74 cm)
9-12M (74-80 cm)
12-18M (80-86 cm)
18-24M (86-92 cm)
2-3Y (92-98 cm)
Size Guide
Learn More
Shopping Security
Safe Payments
Privacy Protection
